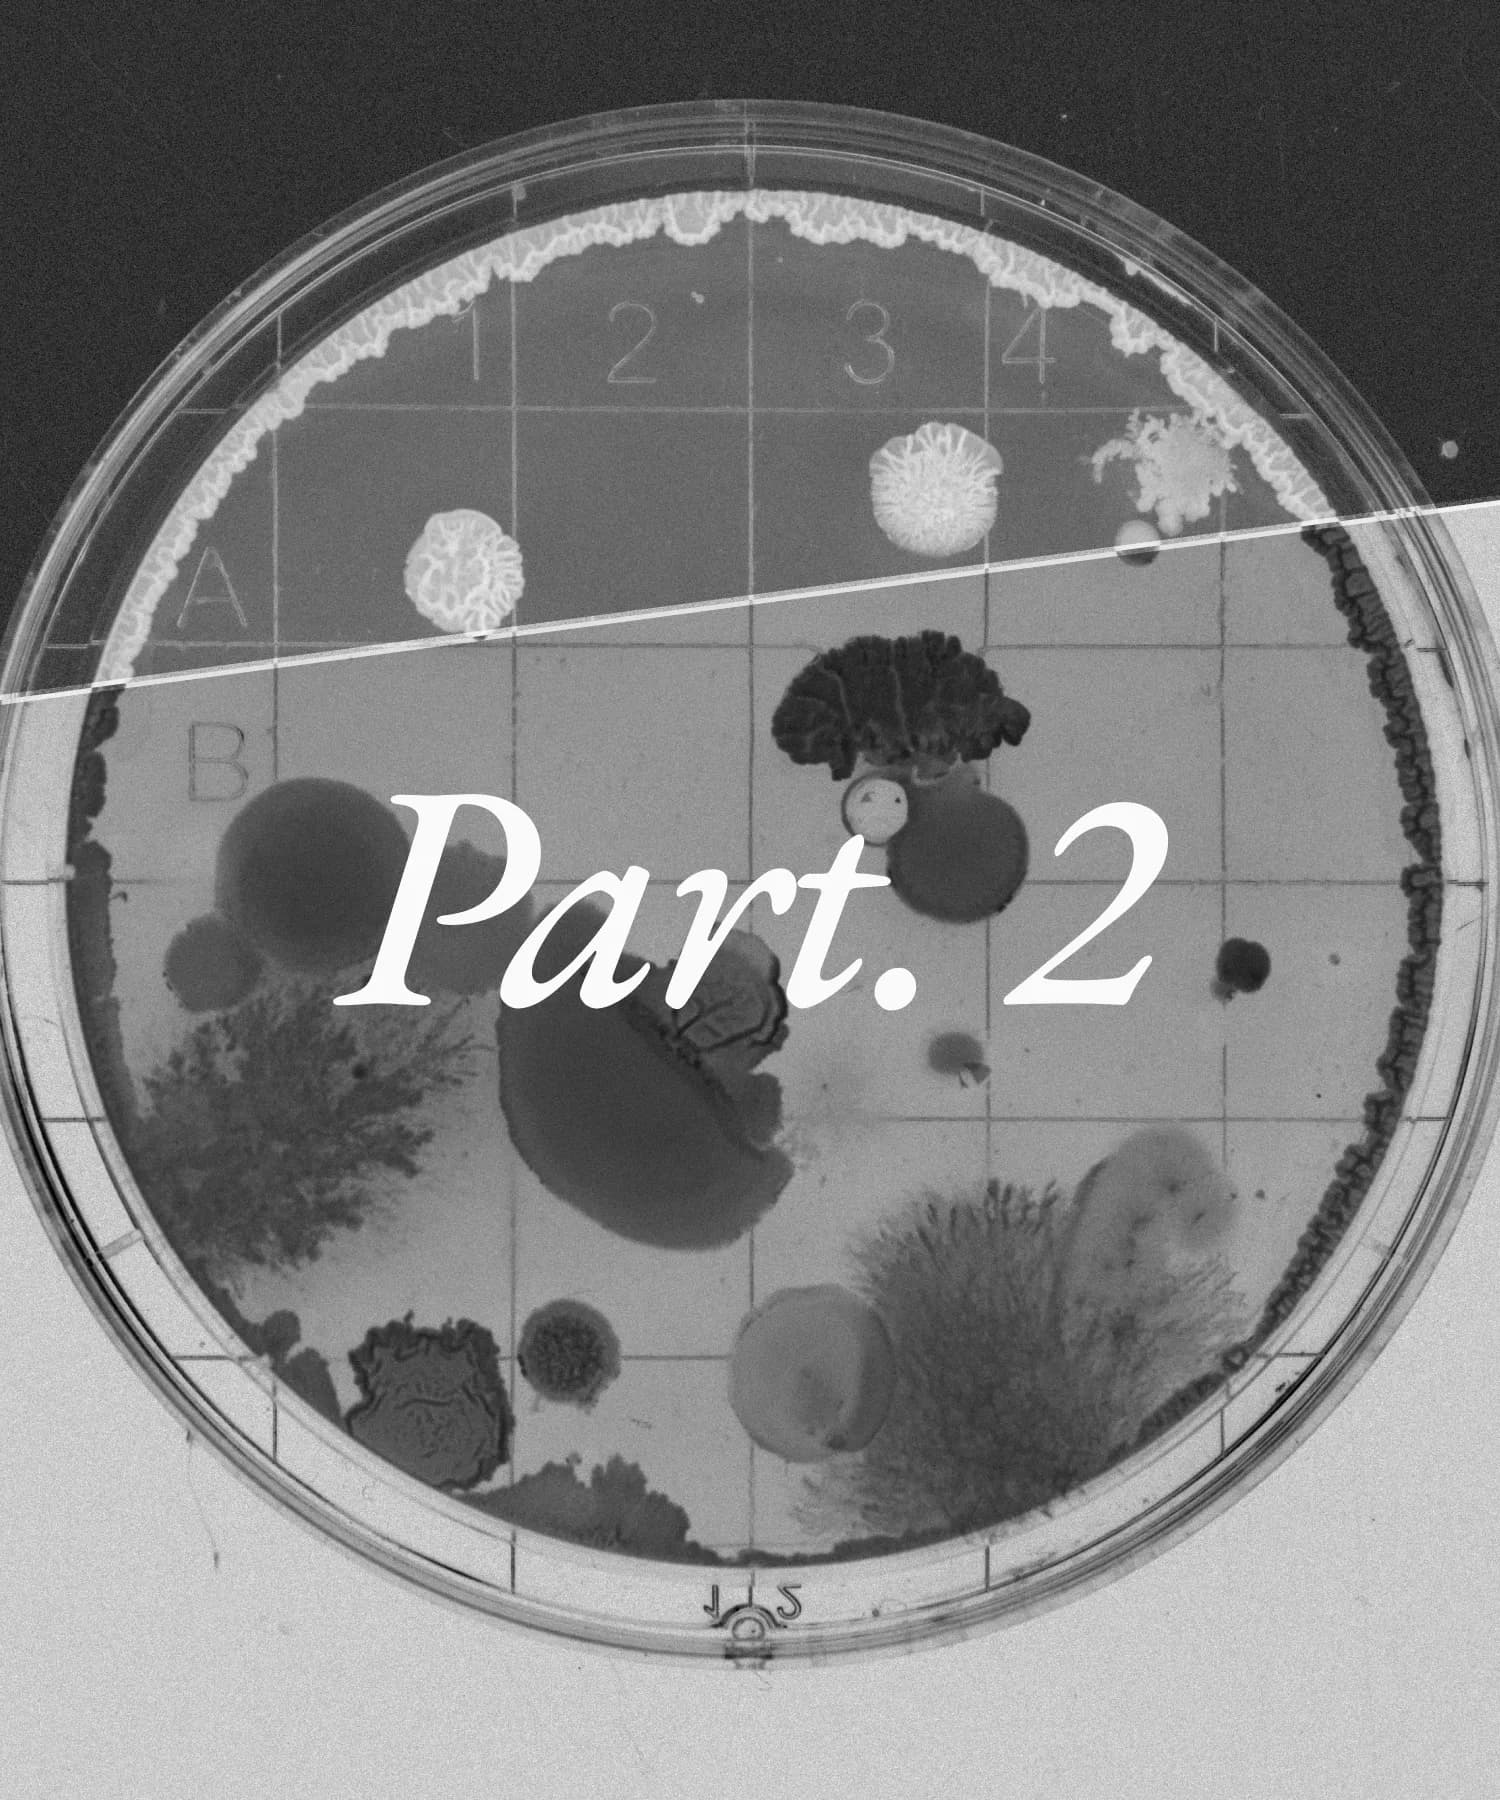
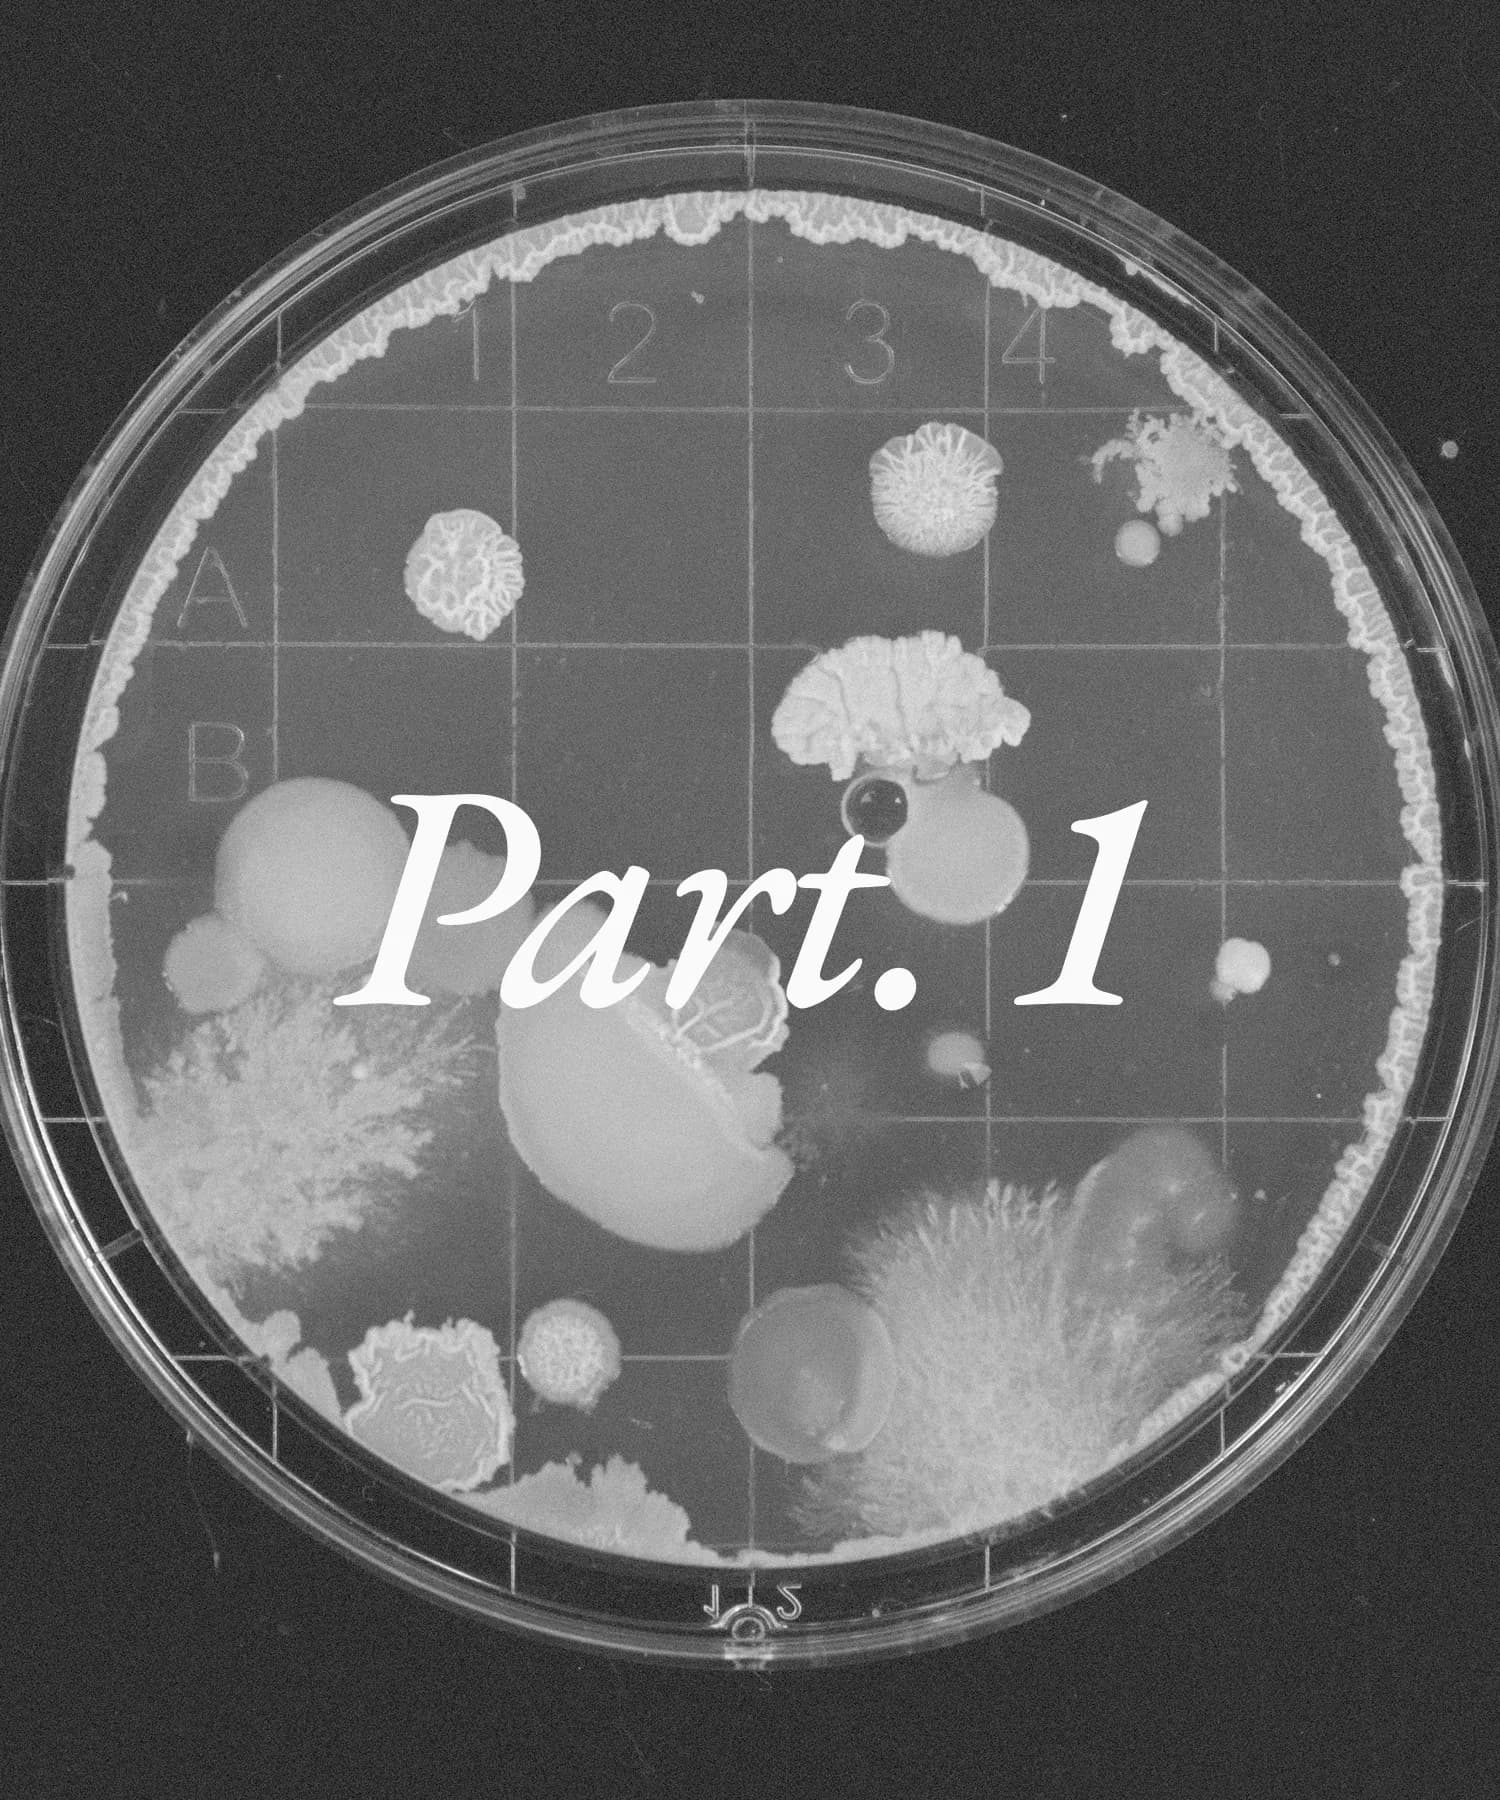
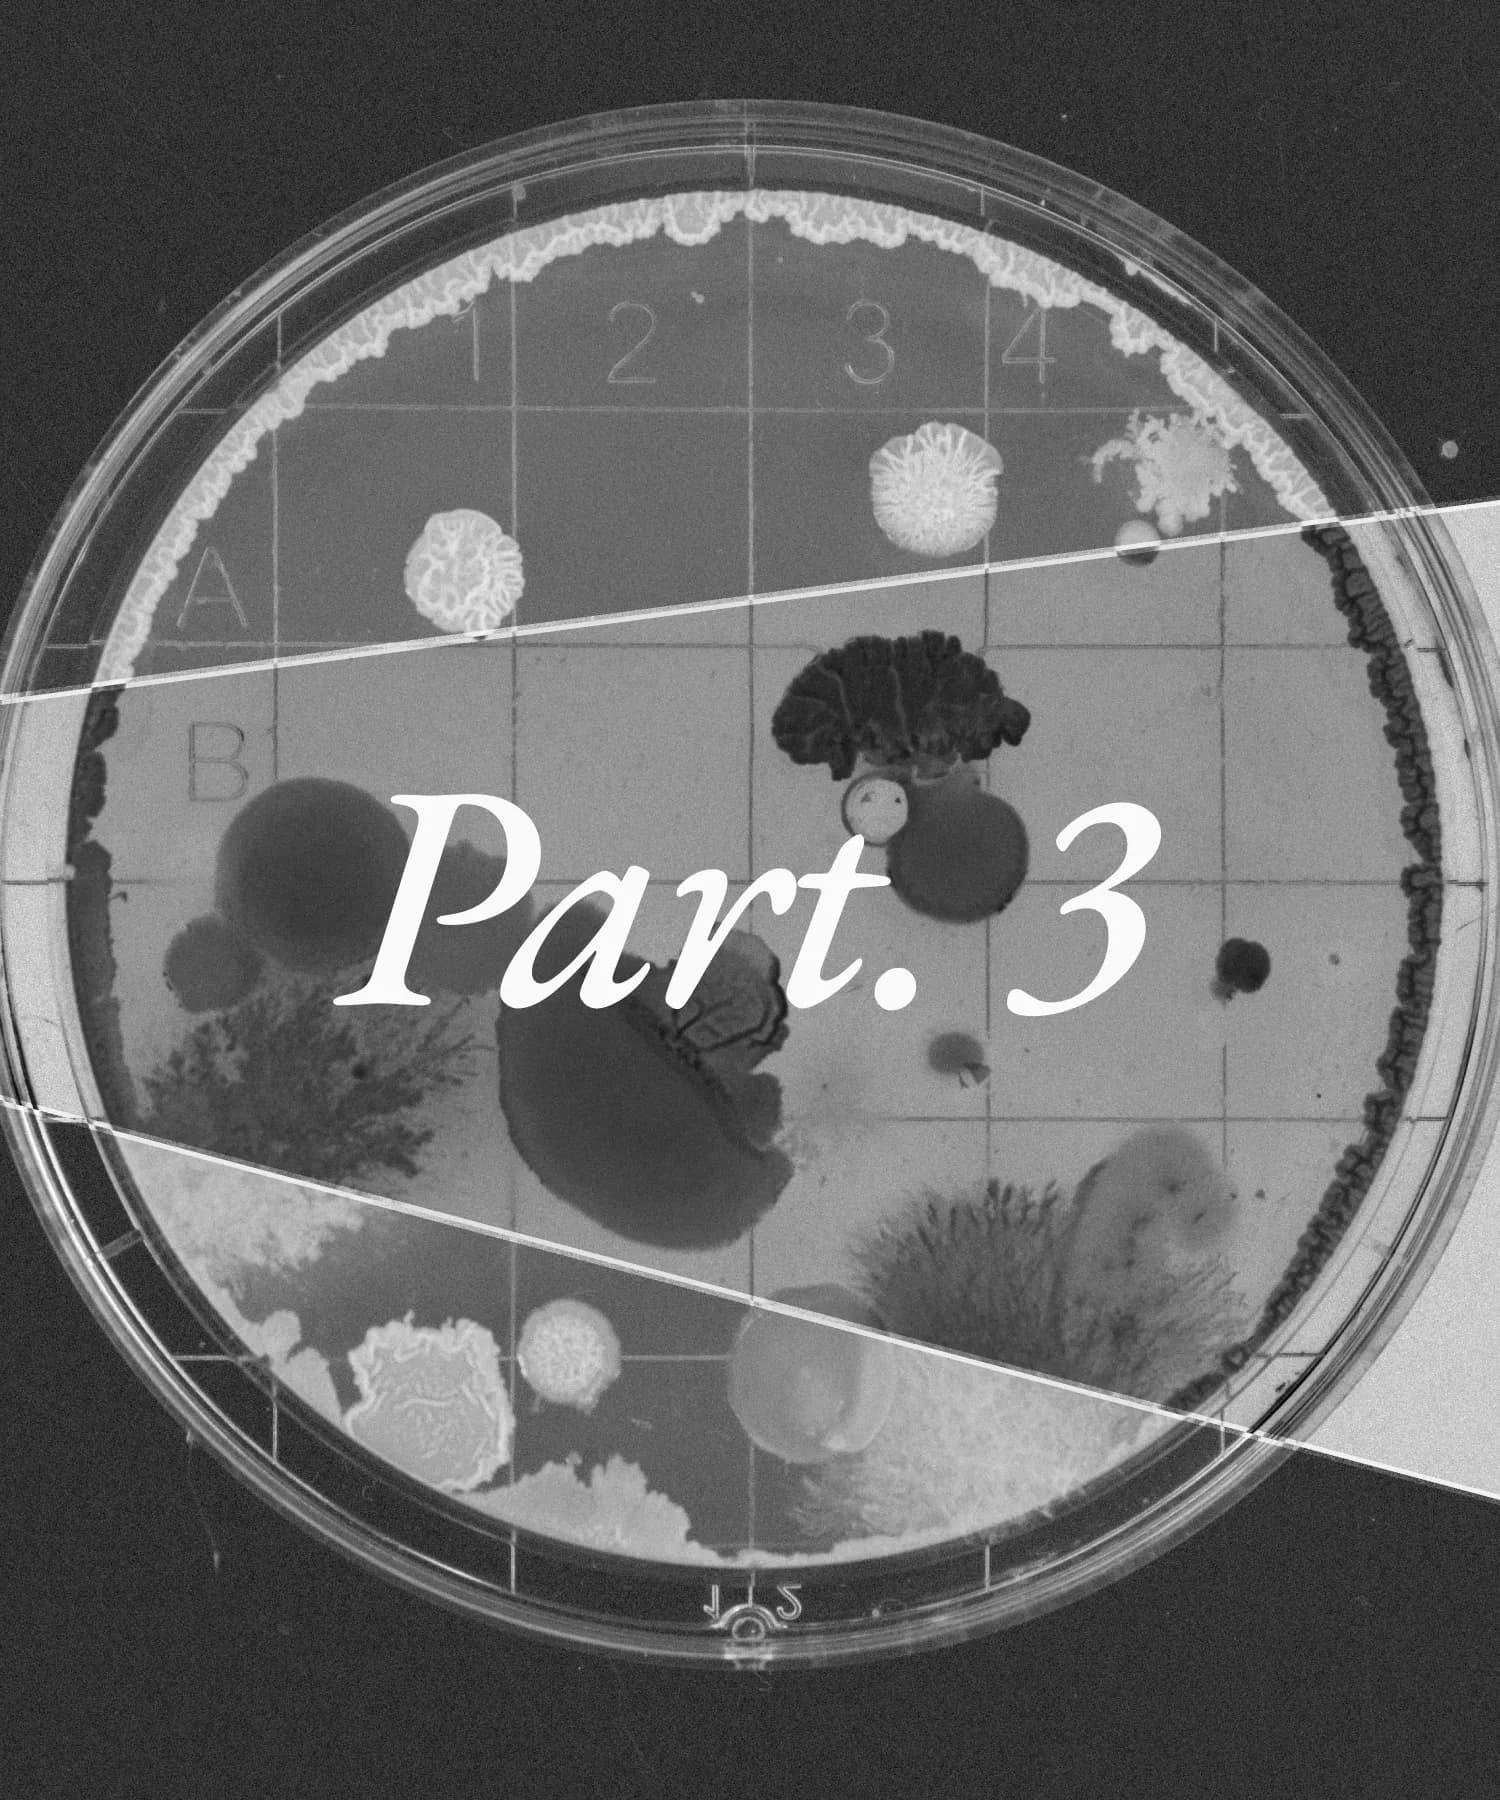

$5,000
BTC Implied Volatility Prediction Competition

Ends 3/18/26
Predict the 30-day implied volatility (DVOL) of Bitcoin using the Deribit volatility index.
1,000 $USDC/week
DataCrunch Equity Market Neutral #2

This weekly cross-sectional problem target the expected returns of the 3000 most liquid US equities.
6,000 $USDC/quarter
ADIA Lab Structural Break Open Benchmark Challenge

Ends 12/18/26
Detect structural changes in time series data for accurate insights.
50,000 $USDC/year
Obesity ML Competition: Tackling Metabolic Diseases - Part 1

Ends 5/1/26
Can you design algorithms that identify genes driving obesity and metabolic disease?
10,000 $USDC/month
Falcon: The Collective Pricing Engine

Can you outsmart the falcons and predict where the dove will go next?
$120,000/year
DataCrunch Equity Market Neutral

Ends 12/11/25
This weekly prediction contrast ranks 3000 most liquid US equities for DataCrunch's Hedge Fund.
π Points
π the Modern AI Challenge
Query the world’s data, find unique insights, world-changing correlations and earn money from financial institutions
Copyright © 2025 Crunch Lab Inc. All rights reserved.
36 Manchester Drive, Westfield, New Jersey, 07090, United States